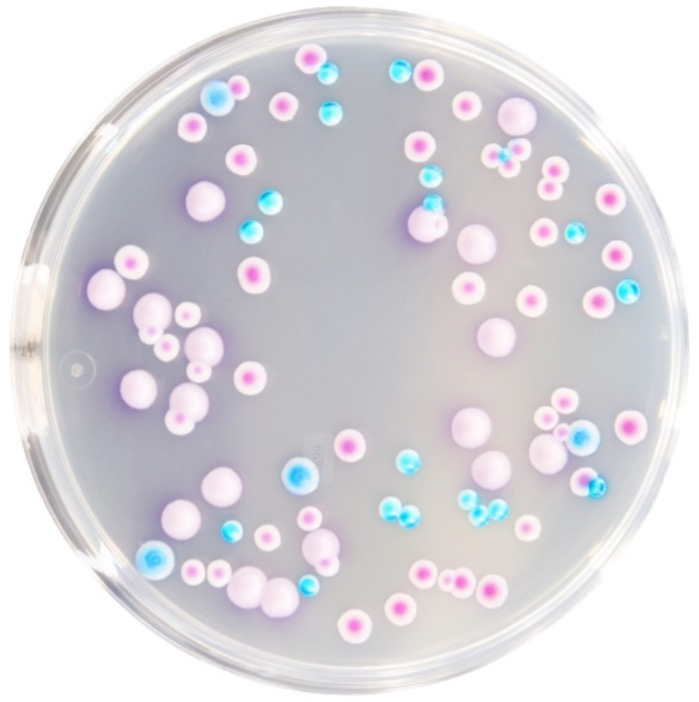

CRM016B Chromogenic Candida Agar
$372-571
Product No.Product CategorySpecificationCRM016BDehydrated Culture Medium500g/bottle Intended Use For the selective isolation and presumptive identification of Candida, particularly Candida al……
Introduction
| Product No. | Product Category | Specification |
| CRM016B | Dehydrated Culture Medium | 500g/bottle |
Intended Use
For the selective isolation and presumptive identification of Candida, particularly Candida albicans.
Principle and Interpretation
Peptone provides carbon and nitrogen sources.Agar acts as the solidifying agent for the culture medium.Chloramphenicol inhibits the growth of contaminating microorganisms.Chromogenic substrates specifically react with enzymes produced by Candida.hydrolyzing the substrate to release a chromogen. Candida albicans forms green to blue-green colonies due to its enzymatic activity.
Formulation
| Ingredients | /liter |
| Peptone | 10.2g |
| Chromogen Mixture | 22.0g |
| Agar | 15.0g |
| Chloramphenicol | 0.5g |
| pH 6.3±0.2 at 25°C | |
Preparation
Weigh out 47.7 g of this medium, add it to 1000 mL of distilled or deionized water, stir, heat, and bring to a boil until completely dissolved. Once cooled to approximately 50℃, pour into sterile Petri dishes under aseptic conditions. Allow the medium to solidify before use.
Quality Control
Cultural characteristics observed after incubation at 30-35°C for 48-72 hours
| Quality control strains | Approx. Inoculum(CFU) | Recovery | Characteristics |
| Candida albicans ATCC 10231 | 10-100 | PR:0.5-2.0 | Green-blue-green colonies |
| Candida krusei ATCC 34135 | > 104 | – | Purple-red colonies, irregular edges |
| Candida glabrata ATCC 15126 | > 104 | – | Pink periphery with purple-red center |
| Candida tropicalis ATCC 1369 | > 104 | – | Steel-blue colonies |
| Escherichia coli CMCC(B)44102 | > 104 | G≤1 | No growth |
Storage and Shelf Life
2-30℃,Keep container tightly closed, avoid direct sunlight.
Use before expiry date on the label.
Precautions
1. When weighing the dehydrated medium, please wear masks to avoid causing respiratory system discomfort
2. Keep container tightly closed after using to prevent clumping.
Waste Disposal
Microbiological contamination was disposed by autoclaving at 121°C for 30 minutes.
Revision
On June 14, 2024
Candida albicans: Green-blue-green coloniesOther microbes: Magenta colonies, steel-blue colonies, or inhibited/no growth



